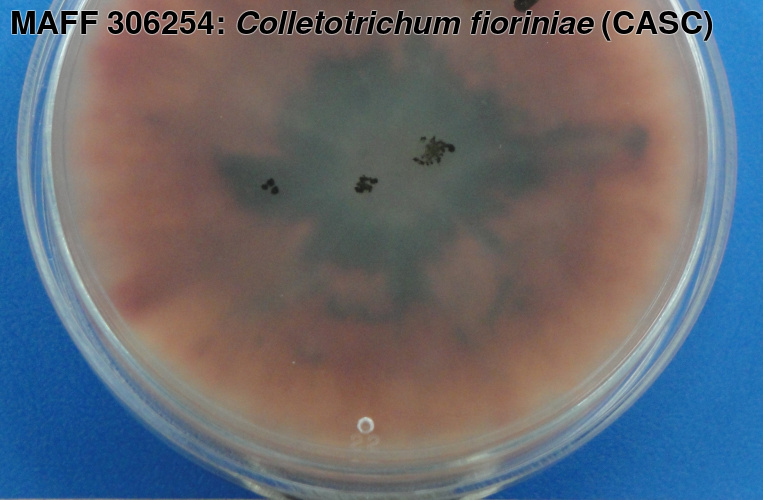
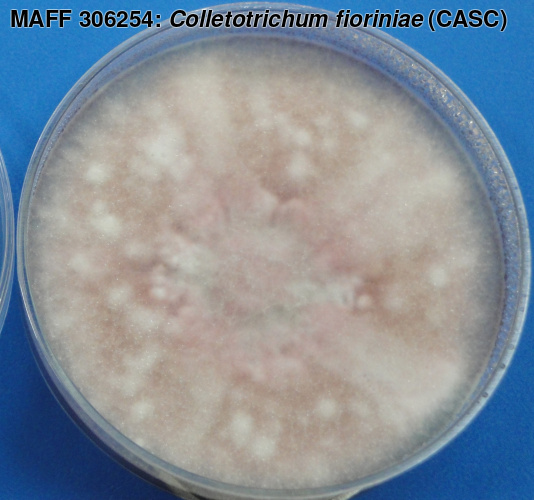

MAFF 306254の詳細
| MAFF番号 | 306254 |
| 微生物種類 | 糸状菌 |
| 学名 | Colletotrichum fioriniae (Marcelino et Gouli) R.G. Shivas et Y.P. Tan (CASC) |
| 再同定者 | 佐藤豊三 (更新: 2011/04) |
| 登録時学名 | Colletotrichum acutatum J.H. Simmonds |
| 同定者 | 佐藤豊三 |
| 分離源 | トルコギキョウ |
| 採集地 | 宮崎 (宮崎市) |
| 採集日 | 1991/05 |
| 分離者 | 溝口一美 |
| 提供者 | 溝口一美 |
| 株名 | To9107 |
| 培地 | Potato dextrose agar (hand made) (Potato 200g for decoction, Glucose 20g, Agar 17-20g, Distilled water 1000ml) |
| 培養適温 | 18℃ |
| 特性 | 病原性 () |
| 塩基配列 | ITS β-tubulin |
| 写真データ | |
| 文献 | - Sato, T., Moriwaki, J. and Misawa, T. (2013). Molecular re-identification of strains of the Colletotrichum acutatum species complex deposited in the NIAS genebank and morphological characteristics of its member species. Japan Agricultural Research Quarterly : JARQ 47(3): 295-305. [10.6090/jarq.47.295]
- 佐藤豊三・森脇丈治 (2003). 多犯性植物炭疽病菌Colletotrichum acutatum. 微生物遺伝資源利用マニュアル 13: 1-12. [gene.affrc.go.jp]
- 佐藤豊三・森脇丈治 (2013). 広義Colletotrichum acutatumの種分割と炭疽病の病原再同定. 植物防疫 67(2): 113-120. [jppa.or.jp]
- 佐藤豊三・溝口一美・植松清次・三浦猛夫 (1992). Colletotrichum acutatum によるトルコギキョウ炭そ病(新称). 日本植物病理学会報 58(4): 544. [jstage.jst.go.jp]
- 杉山 悟・佐藤豊三・森脇丈治・景山幸二・忠 英一 (2008). Colletotrichum acutatumによるワレモコウ炭疽病(新称). 北日本病害虫研究会報 59: 86-89. [10.11455/kitanihon1966.2008.86]
|
| 配布申込 | 申込 |